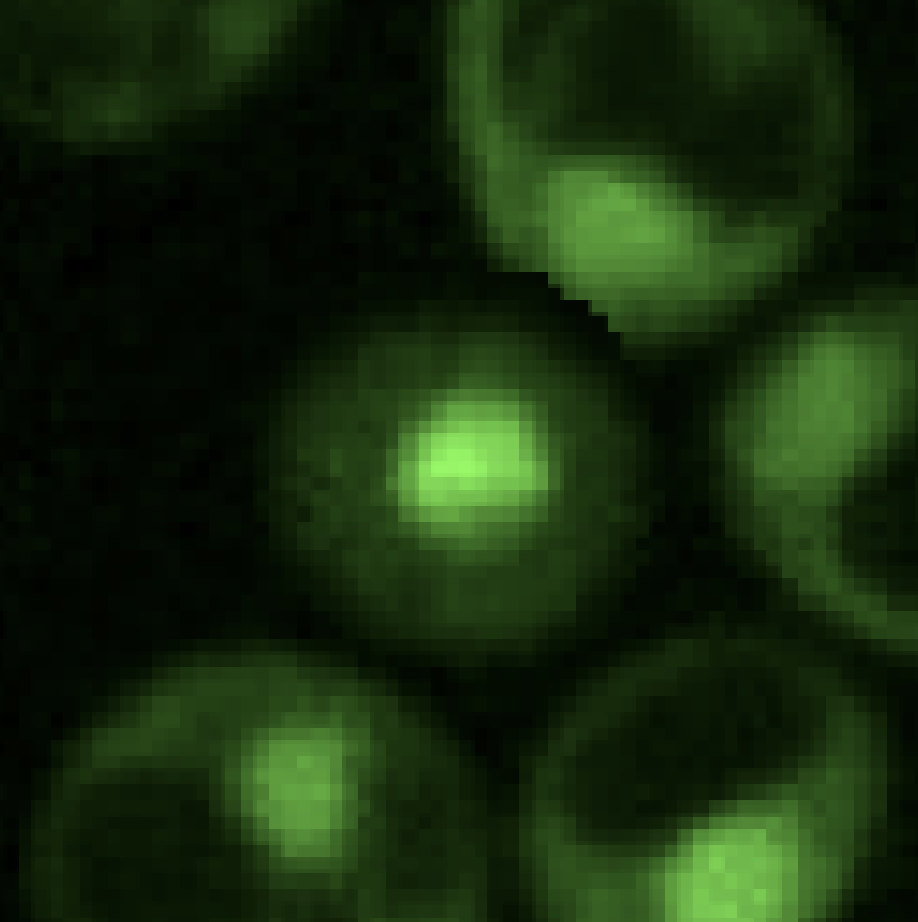
background_cells.png

Arushi Gupta
Department of Computer Science, Stanford University.
I’m a first-year CS PhD student at Stanford, fortunate to be co-advised by James Zou and Jiajun Wu. I am broadly interested in developing multimodal intelligence and its scientific applications. My research is graciously funded by the NSF Graduate Research Fellowship.
Previously, I graduated with a degree in CS from Caltech in 2025, advised by Anima Anandkumar. I spent wonderful summers working with Alex Lu (Microsoft Research), Shreyas Vasanawala (Stanford), and Andrew Hung (Cedars-Sinai).
I’m always happy to chat about research or anything else. Feel free to reach me at arugupta[at]stanford.edu!
Selected Publications
-
 Multi-Modal Self-Supervised Learning for Surgical Feedback Effectiveness AssessmentMachine Learning for Health Symposium (PMLR), 2024
Multi-Modal Self-Supervised Learning for Surgical Feedback Effectiveness AssessmentMachine Learning for Health Symposium (PMLR), 2024
Teaching & Outreach
Outside of research, I really enjoy teaching and mentorship! Over the past few years, I've been lucky to have the chance to work with students across a range of courses and settings.
Teaching Assistant, Caltech · Winter 2025
Teaching Assistant, Caltech · Spring 2023, Spring 2024
Teaching Assistant, Caltech · Winter 2023
Teaching Assistant, Caltech · Fall 2023
Grader, Caltech · Fall 2022
Campus Representative, Caltech · Outreach & mentorship for women in CS.
Co-Founder · 100k+ enrollments across free STEM courses and camps.